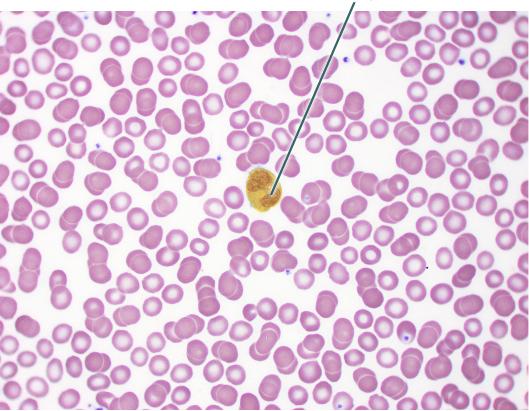

Which structure is highlighted?
interosseous border

Which structure is highlighted?
perisoteal bone collar

Which structure is highlighted?
pubic symphyseal fossa

Which tissue is highlighted?
elastic cartilage

Which structure is highlighted?
sternal end

Which region is highlighted?
petrous

Two major muscles innervated by the highlighted nerve are the ________.
vastus lateralis and vastus medialis

What muscle structure is continuous with the highlighted tissue?
tendon

Which structures are highlighted?
spinous processes

The highlighted organ secretes which of the following hormones in response to growth hormone?
IGF-1

Which hormone does the highlighted organ secrete in response to hypoxia?
erythropoietin

What are the actions of the highlighted muscle?
abduction and extension of thumb

What mechanism allows for a contraction of the highlighted cell?
sliding filament

Which structure is highlighted?
sympathetic trunk

The highlighted structure articulates with which of the following bones?
talus

Which structure is highlighted?
vertebral foramen

Which structure is highlighted?
medial epicondyle

Which structure is highlighted?
skeletal muscle fiber

Which structure is highlighted?
costal groove

The highlighted structure articulates with which structure and bone?
radial notch of the ulna

Which muscle is highlighted?
omohyoid

________ is a condition characterized by the exaggerated lateral bending of the highlighted structure.
Scoliosis

True or false. The highlighted bone articulates with a thoracic and lumbar vertebra.
True

Which structure is highlighted?
coronoid process

Which of the following muscles originates on the highlighted bone?
deltoid

What is an action of the highlighted muscle?
extends thigh at hip

Which structures are highlighted?
true ribs

Which structure is highlighted?
anterior fontanelle

Which muscle is highlighted?
teres major

Which muscle is highlighted?
fibularis longis

Which structure is highlighted?
auricular surface

Which muscle is highlighted?
extensor digiti minimi

Which bone is in the image?
femur

Which cranial nerve is highlighted?
trigeminal nerve

Which structures are highlighted?
acromia

Which tissue is highlighted?
endoneurium

Which of the following muscles originates on the highlighted structure?
rectus abdominis

What structure is highlighted?
cartilaginous epiphysis

Which of the following is true regarding the highlighted structure and the associated bone?
develops from the formation of ossification centers within mesenchymal tissue

Which two cranial nerves are highlighted?
glossopharyngeal and vagus

What term is used to refer to the highlighted epithelium in a blood vessel?
endothelium

True or false. The highlighted bone articulates with the ulna.
False

Which structure is highlighted?
medial border

Which structures are highlighted?
palmar digital branches of the median nerve

Which structure is highlighted?
lumbar curvature and vertebra
Which of the following is a function of the highlighted cell?
phagocytosis

Which nerve is highlighted?
ulnar

Which structure is highlighted?
umbilicus
Lack of thyroid hormone in a newborn infant leads to what type of disorder?
cretinism

Which nerve is highlighted?
vestibular

Which structure is highlighted?
greater sciatic notch

The highlighted nerve plays what role in the parasympathetic nervous system?
pupil constriction

What is a function of the highlighted structures?
allows action potentials to quickly travel from one cell to another
The highlighted bone and the hip bone form what type of synovial joint?
ball and socket

Which cranial nerve is highlighted?
facial

Which cells are highlighted?
satellite cell

The highlighted structure articulates with which of the following?
head of the rib

Which tissue is highlighted?
white matter

The highlighted fibers are produced by what cell type?
fibroblast

Which structure is highlighted?
ovary

Which structures are highlighted?
occipital condyles

Which cranial nerve is highlighted?
abducens nerve (VI)

Which structures are highlighted?
nuclei

The highlighted structure is continuous with the ________ of the ilium and the ________ of the pubis to form the pelvic brim.
arcuate line; pubic crest

Which structure is highlighted?
olfactory tract

Which structure is highlighted?
striation

Which gland is highlighted?
thyroid

Which structure is highlighted?
acetabular labrum

True or false. The bone in this image directly articulates with all 12 ribs.
False

Which surface is highlighted?
articular tubercle

Which vessel is highlighted?
thoracic aorta

Which muscle is highlighted?
vastus intermedius

What is an action of the highlighted muscle?
depresses hyoid

Which muscle is highlighted?
levator labii superioris

Which nerve is highlighted?
vestibulocochlear

The highlighted structure is an important clinical marker. What is its significance?
aligns with the superior border of the heart

Which structure is highlighted?
iliac crest

Which structure is highlighted?
foramen rotundum

True or false. The highlighted structure directly articulates with the ischium of the coxal bone.
False

Which structures are highlighted?
dorsal roots of spinal cord

Which structure is highlighted?
corpus callosum

Which structure is highlighted?
ala

Which structure is highlighted?
inferior articular process

Which structure is highlighted?
superior ramus of pubis

Which structure is highlighted?
median sacral crest

How would you classify the group of highlighted bones?
long

What is secreted by the highlighted cell?
mucin

Which structures are highlighted?
cell bodies of Purkinje cells

Which structures are highlighted?
Schwann cell nuclei

Which structure is highlighted?
brainstem

When does the highlighted curvature develop?
at the time that a child is able to sit up

Which muscle is highlighted?
anterior scalene

Which nerve innervates the highlighted muscle?
radial

Which nerve is highlighted?
left vagus

The highlighted muscle originates from which of the following structures of the cranium?
temporal fossa

Which structure is highlighted?
crista galli

Which structure is highlighted?
transverse process

Which muscles are highlighted?
rectus capitis posterior major

Which structures are highlighted?
dorsal root ganglia

The highlighted muscle flexes the interphalangeal joints of digits ________.
2-5

Which muscle is highlighted?
Flexor digiti minimi brevis

Which structure is highlighted?
anterior crest

Which structure is highlighted?
mastoid process

Which structures are highlighted?
microvilli

Which structures are highlighted?
superior articular facet

Which muscle is highlighted?
flexor hallucis longus

What is a primary function of the highlighted structure?
coordination of movement

Which structure is highlighted?
sternal end

Which joint is highlighted?
distal tibiofibular

Which muscle is highlighted?
subcostalis

Which nerve is highlighted?
deep fibular

Which joint is highlighted?
acromioclavicular

Which bone is in this image?
sternum

Which structure is highlighted?
costal tubercle

Which structure is highlighted?
pineal gland

The highlighted structures innervate which of the following?
deep muscles of thorax

What is the action of the highlighted structure?
elevates eye and turns it laterally

Which of the following best describes the function of the highlighted structure?
allows lateral rotation of the head

What structure connects the highlighted muscle cells to one another?
intercalated discs

Which lobe is highlighted?
occipital

Which structure is highlighted? (124)
cornea

Which structure is highlighted?
sclera

True or false? Fibroblasts can be found within the highlighted structure.
True

Which epithelial type is highlighted?
transitional epithelium

Which structures are highlighted?
optic tracts

What is the action of the highlighted muscle?
raises eyebrows

Which structure is highlighted?
lateral epicondyle